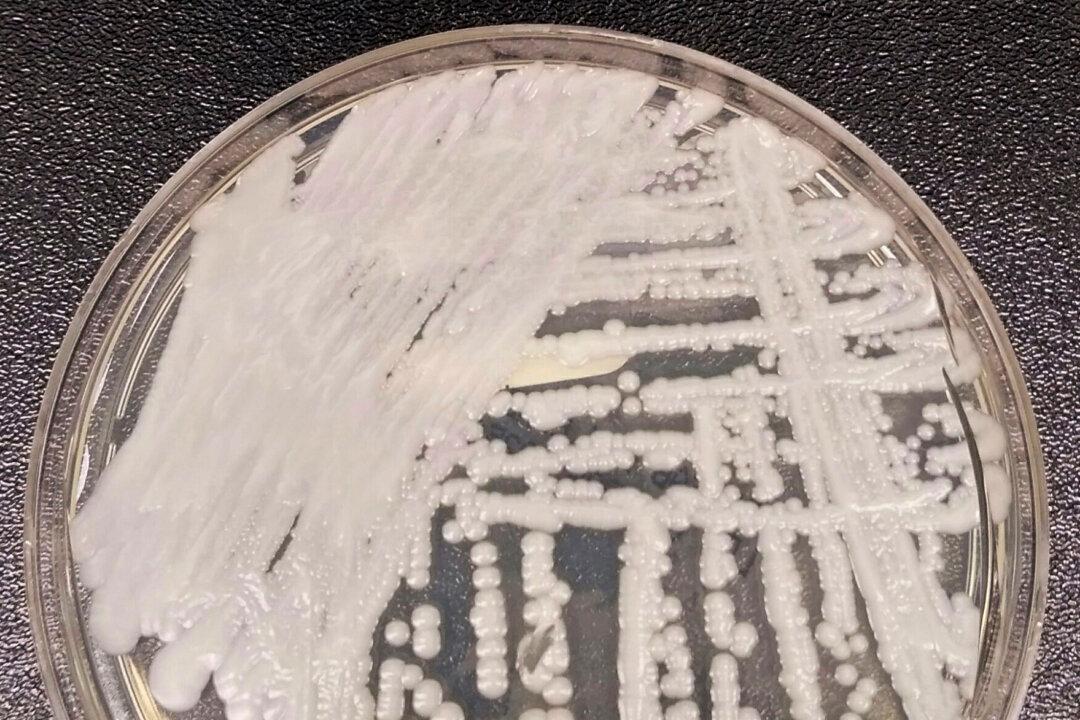
‘Superbug’ Fungus Spread in Two Cities, Health Officials Say

NEW YORK—U.S. health officials said Thursday they now have evidence of an untreatable fungus spreading in two hospitals and a nursing home.
The “superbug” outbreaks were reported in a Washington, D.C, nursing home and at two Dallas-area hospitals, the Centers for Disease Control and Prevention reported. A handful of the patients had invasive fungal infections that were impervious to all three major classes of medications.